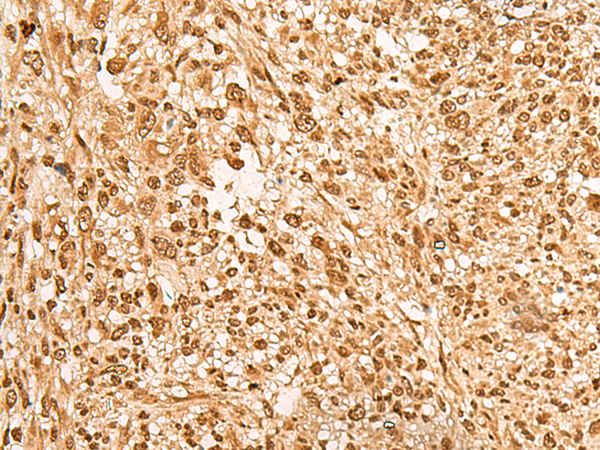
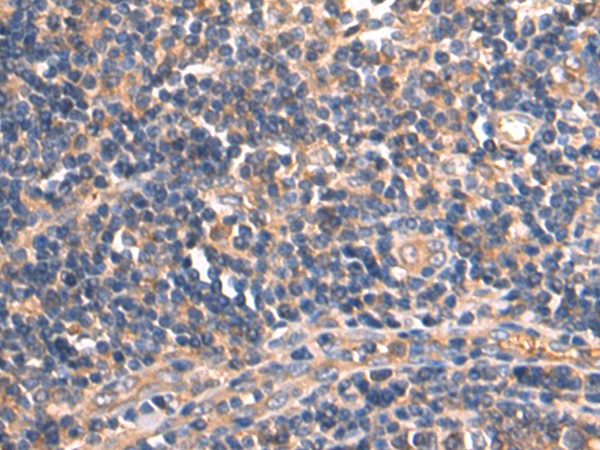

-
分类: 科研抗体货号: P09849别名: SRCRB4D; S4D-SRCRB; SRCRB-S4D应用: IHC反应种属: Human
-
分类: 科研抗体货号: P09848别名: L11; HN1L; C16orf34应用: IHC反应种属: Human
-
分类: 科研抗体货号: P09868别名: HPRT; HGPRT应用: WB,IHC反应种属: Human, Mouse, Rat
-
分类: 科研抗体货号: P09847别名:应用: IHC反应种属: Human
-
分类: 科研抗体货号: P09867别名: MAI; MAAI; MAAID; GSTZ1-1应用: WB,IHC反应种属: Human, Mouse, Rat
-
分类: 科研抗体货号: P09846别名: MTQ2; HEMK2; N6AMT; PRED28; C21orf127; m.HsaHemK2P应用: IHC反应种属: Human
-
分类: 科研抗体货号: P09865别名: PC-TP; STARD2应用: WB,IHC反应种属: Human, Mouse
-
分类: 科研抗体货号: P09845别名: L17; PD-1; RPL23应用: WB,IHC反应种属: Human, Mouse, Rat
-
分类: 科研抗体货号: P09864别名: RDCVF; TXNL6应用: WB,IHC反应种属: Human
-
分类: 科研抗体货号: P09843别名: L18mt; HSPC071; MRP-L18应用: WB,IHC反应种属: Human, Mouse

鄂公网安备42018502007531号
鄂公网安备42018502007531号

